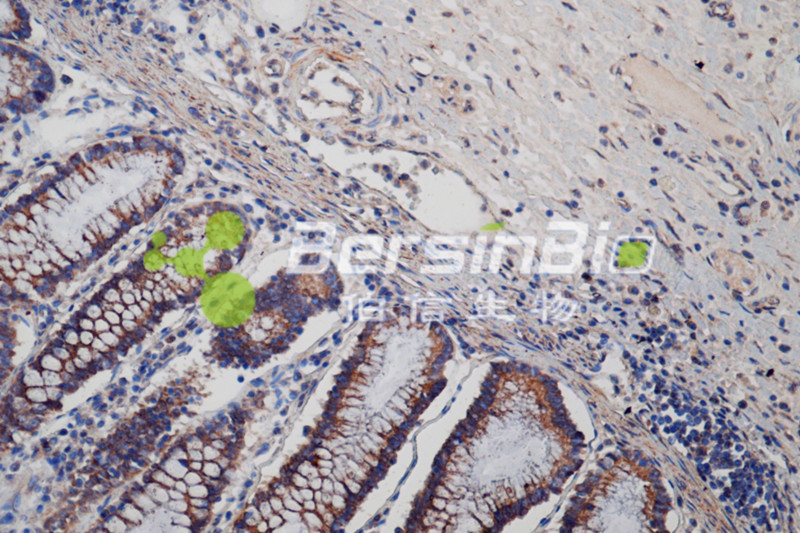

免疫组化(IHC)
发布时间 :2017-12-26
原位确定特定蛋白质的分布和含量。
免疫组织化学(Immunohistochemistry)又称免疫细胞化学,是根据抗原抗体反应和化学显色原理,组织切片或细胞标本中的抗原和一抗结合,再利用一抗与标记生物素的二抗进行反应,前者再用标记辣根过氧化物酶(HRP)或碱性磷酸酶(AKP)等的抗生物素(如链霉亲和素)结合,最后通过呈色反应在光学显微镜下可清晰看见细胞内发生的抗原抗体反应物,从而原位确定特定蛋白质的分布和含量。

客户提供
① 组织:新鲜或固定(10%中性甲醛、4%多聚甲醛)组织样本;
② 细胞:新鲜(大于106)或固定(10%中性甲醛、4%多聚甲醛)细胞样本;
③ 切片:石蜡切片,冰冻切片以及细胞爬片,涂片;
④ 实验材料:一抗;
伯信提供
① 染色后的切片;
② 电子图片(光学显微镜拍照);
③ 实验报告(实验仪器、试剂、方法、结果、结论)。


ICC 人肺腺癌细胞 cyclinD1 200×
IHC 人结肠癌组织 目的蛋白 200×



